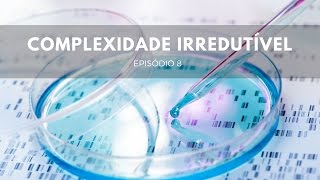

Camuflagem e Mimetismo | Origens #7
98.46k views3445 WordsCopy TextShare

Origens NT
Este é sem dúvida um dos programas mais intrigantes e curiosos desta nossa temporada. Você vai se su...
Video Transcript:
[Música] representar é uma arte saber replicar no Primor escultural a exata textura ou atingir a Mistura Perfeita de cores para reproduzir tonalidades tal qual a enxergamos é também saber atuar incorporando a aparência o comportamento e como no encanto do teatro transmitir por um relance A Essência pertencente ao outro você sabia que cada uma destas especialidades são desempenhadas também na natureza protagonizadas por espécies tão distintas quanto curiosamente [Música] intrigantes [Aplausos] [Música] [Música] em 1848 o o naturalista Henry Bates veio ao Brasil e Henry Bates 11 anos na Amazônia fazendo expedições e nesse período que ele ficou
observando e coletando animais e plantas Bates observou que havia animais que imitavam outros animais quando Bates observou isso ele cunhou o termo mimetismo que quer dizer imitação vale a pena deixar bastante Claro que existe uma confusão e camuflagem e mimetismo são coisas bem tintas então no no vocabulário Popular se usa sempre a palavra mimetismo né ah o animal mimetiza a planta ah o o bicho pau ele imita um galho Tá certo ele imita mas do ponto de vista científico são fenômenos distintos o mimetismo ele se diferencia da camuflagem porque o mimetismo há uma imitação de
outro ser vivo um ser vivo imita outro ser vivo para obter uma vantagem de sobrevivência enquanto que a camuflagem o objetivo é diferente é se esconder não é imit ningém no máximo imitar o ambiente então por exemplo um bicho pco que parece um pedacinho de galho para qualquer Predador eventual ele não será reconhecido como um inseto será visto como um pedaço da floresta ele imita um graveto com perfeição a textura a cor e as suas patas são semelhantes à gravetos menores que brotam do do corpo o interessante do mitismo da camu é que o animal
não tem que que imitar outro ser vivo ou imitar o seu ambiente apenas do ponto de vista físico ele precisa imitar também do ponto de vista comportamental no caso do bicho pau se você a sopra ou se o vento passa ele vai se mover da mesma maneira que os galhos se movem Então como que pode ele não tá pensando nisso o animal não pensa isso tudo é instintivo existe muitas mariposas com mimetismos e camuflagens as mais impressionantes uma delas é uma mariposa que as asas imitam cabeças de cobra cabeças de serpentes quando ela fecha as
asas fica como duas cabeças de serpentes paralelas e qualquer Predador que Tente se aproximar da Mariposa vai ver duas serpentes se assusta e não se aproxima e Olha como a coisa é é é é perfeita assim a mariposa que imita a vespa ela não tem como morder porque mariposas não TM mandíbulas né Como assim como borboletas mariposas só T uma uma trombinha né em forma de canudinho ela só consegue Sugar líquidos Então ela não pode morder como uma vez poderia e também não pode ferroar como a vespa ferraria que é o que realmente dói é
a ferroada né da vespa pelo ferrão porque a mariposa não tem ferrão então além delas serem perfeitamente eh imitadoras de uma vespa algumas mariposas quando você pega na mão Elas começam a mover o abdômen fazendo movimento como se fosse ferroar o Predador né ou no caso uma pessoa que manipule se a pessoa pega ela começa a fazer esse movimento ou se o animal né que vai predar essa Mariposa pega ela ou com as com os membros ou com a boca ela começa a fazer o movimento como se fosse ferroar o primeiro reflexo é soltar antes
de qualquer coisa porque é o reflexo que nós temos quando uma formiga uma vez Tent trans ferroar se o animal percebe que é enganado ou não Não importa esses segundos que o animal solta como reflexo a tentativa de aferroar que nunca aconteceria pode ser o suficiente para escapar para sempre então a riqueza da imitação se dá até na maneira como o animal se comporta a gente costuma ver algumas mariposas que elas têm desenhos muito bem feitos nas suas asas imitando óleos de pássaros principalmente óleos de coruja a coruja é um Predador uma ave que que
carnívora e ela ataca muitos animais Ah então alguns animais que são predadores de mariposas ao verem a mariposa com as asas abertas apresentando essas esses desenhos ele confunde facilmente com o rosto de uma coruja e se assusta e Foge porque a coruja é uma ameaça para ele alguns insetos principalmente mariposas que imitam folhas chegam ao nível de detalhe de imitar também a o tipo de folha de uma determinada espécie de planta que quando cai da planta e resseca ela se enrola e ela também imita o enrolar da folha várias espécies de louv a Deus um
insetinho bem conhecido a gente só que a gente conhece ele como um insetinho verde né e o louv a Deus ele é um Predador muito muito voraz come vários outros insetos alguns bichinhos da Mata Então o louv Deus ele se protege se camufla aquele típico louv Deus verdinho ele já é uma espécie de camuflagem para ele se proteger tanto de predadores como se esconder das presas e surpreendê-los com mais facilidade no meio de uma vegetação Verde evidentemente mas existem outros tipos de louv a Deus com outro tipo de camuflagem como louv a Deus que é
ele imita as pétalas de uma de uma flor uma flor que tem pétalas rosadas ou lilás por exemplo ele vai mostrar o corpo imitando essa flor é muito [Música] interessante existem vários tipos de insetos que imitam folhas não só folhas vivas mas também folhas secas são folhas que caem das Árvores secam no chão ficam escuras marrons Ah o processo de decomposição da folha provoca manchas de na na própria folha a as beiradas da folha ficam comidas e os esses insetos imitam essas folhas com requintes de perfeição cada detalhezinho aparece ali as beiradas comidas as ranhuras
da folha a cor da folha seca a textura as manchas da folha dac composição tudo está lá como é que ele pode chegar a ser tão perfeito tem a aquela veia Central Às vezes tem um um pedacinho dobrado com se fosse uma folha seca muitos tem até Buraquinhos né áreas transparentes que é como se tivessem imitando um um buraco que algum animal comeu a folha como pode acontecer isso né É muito difícil se imaginar que essa espécie de inseto ao longo de milhões de anos conseguiu desenvolver essas características tão precisas iguais a as folhas que
estão ao seu redor através de mutações casuais e modificações corporais que se acumularam ao longo de muito tempo outros insetos Eles imitam detalhes precisos do tipo de galho aonde ele costuma ficar quietinho para passar despercebido a algumas espécies que eles o galho está quebrado partido e eles copiam o miolo do Galho não só a textura e a cor da casca do Galho mas o miolo do Galho partido isso é muito impressionante vários lagartos conseguem se se disfarçar nos galhos das Árvores onde eles habitam eles têm na sua estrutura de pele na sua anatomia na sua
morfologia eles têm não só a cor e a textura do galho da árvore a ponto de eles se confundirem bastante com o próprio galho mas eles também desenvolvem alguns requintes Como por exemplo o musgo im musgo que existe no galho o animal em si não tem musgo o galho tem mas a pele dele tem estruturas que imitam exatamente o musgo para ficar idêntico ao galho existem casos entretanto como é o caso de Alguns lagartos como os camalhões e várias espécies de animais marinhos como povos as sépias outros organismos marinhos também onde a camuflagem Ela atinge
um nível superior na verdade essas espécies TM células no corpo capazes de mudar a coloração do animal inteiro de acordo com o substrato onde ele tá de acordo com o fundo quer dizer se o animal tá num fundo escuro a aparência dele toda a coloração da pele fica mais escura se tá num fundo Claro ela fica mais clara e às vezes como no caso de algumas espécies de Camaleões e de algumas espécies de de polvos não é só a cor que fica mais clara Mais Escura mas o padrão também e essa camuflagem funciona de duas
maneiras no Camaleão por exemplo obviamente que ele está camuflado tá verde contra um fundo cheio de folhas protege ele contra seus predadores camalhões são lagartos que podem ser comidos por animais maiores mas eles também são predadores de insetos então isso também propicia que ele chegue muito próximo da sua presa para poder capturá-la mesmo o caso dos povos os povos podem se proteger dos animais né peixes maiores até dos humanos que os caçam mas o povo é um Predador né as sépias são predadores então elas podem chegar próximos dos organismos que eles vão caçar também disfarçando
sua cor se eles estivessem lá no no oceano e com monte de predador atrás eles são a comida preferida de muitos deles e se não tivesse tudo isso funcionando Eles simplesmente já teriam sido distintos mas não eles têm quatro diferentes estratégias de mimetismo e e camuflagem então de repente no meio ambiente Eles encontram ali uma rocha Eles imitam a cor da Rocha Eles imitam a textura da Rocha quando tem odor Eles imitam o odor do lugar você estão se se camuflando de alga Eles imitam o movimento das algas e são quatro sistemas que tem que
funcionar sincronizadamente e tem que funcionar rapidamente não pode ficar esperando um eh a cor vem primeiro depois vem o a vem a camuflagem de forma depois vem a camuflagem de textura de de odor não você tem que ter tudo aquilo lá quase que instantâneo o O Predador se aproxima eles mudam de cor de textura tudo quase que instantaneamente encostam numa numa rocha numa planta e a gente vai ver isso como que funciona do ponto de vista químico atômico e molecular é espetáculo é é uma um jogo de ótica um jogo de corantes um jogo de
sinais elétricos é uma central multimídia eh coordenando tudo isso e dispara uma série de impulsos elétricos impulsos químicos físico-químicos físicos e o bicho instantaneamente se transforma numa pedra e tudo não tem nada que não diga que aquilo ali é uma pedra mesmo todas as características de uma pedra todas as características de uma alga é isso que a gente chama de complexidade irredutível é uma complexidade que não dá para diminuir não dá para imaginar que aquele bicho lenta gradual e sucessivamente adquiriu primeiro a camuflagem de cor depois a camuflagem de textura depois a camuflagem de forma
o mimetismo e tudo mais teria que est tudo presente desde o início do ponto de vista evolutivo que demora milhões de anos para a mudança acontecer são tantas mudanças no sistema visual no sistema muscular no sistema fisiológico geral no sistema nervoso no sistema de cores de pele dos cromatóforos e tudo mais que tudo isso tendo evoluído a partir de mutações casuais ao longo de milhões de anos milhares e milhares de mutações selecionadas por por um ambiente que está em constante mudança isso é matemática e cientificamente [Música] impossível um caso que que eu acho brilhante para
citar é de uma mariposa como sempre as mariposas que ela tem o desenho em cada asa tem o desenho de moscas e as duas moscas uma de cada lado está comendo excremento de pássaro é impressionante como é que essas figuras de moscas foram parar nas asas dessas mariposas e não é só isso como é que a figura do excremento de pássaro Foi parar lá e as moscas estão como que sugando o excremento e isso é para impressionar algum Predador que se afastaria de tal situação e não é só isso a mariposa também libera um cheiro
um odor de fezes de excremento e aquilo afasta O Predador como que organismos né E vão pensar em animais que são os exemplos mais conhecidos como organismos tão diferentes que não são aparentados podem convergir para se tornarem Tão Iguais e como por um lado no mimetismo por outro lado na camuflagem como que também organismos tão diferentes um gafanhoto e uma borboleta e ou um um sapo ou um lagarto como é que todos eles podem por exemplo imitar uma folha né então e essa pergunta intrigava naturalistas desde o início obviamente que hoje a gente conhece né
com base em no que a gente sabe sobre evolução e sobre seleção natural e adaptação que ao longo do tempo e a vantagem deesse por exemplo desse parecer com ambiente Então logo camuflado se ela começa a aparecer num grupo ela pode ser selecionada e isso com o tempo milhares milhões de anos pode levar com que grupos muito distintos tenham ao final o mesmo resultado por exemplo parecerem uma folha isso nos provoca nos desafia a esse questionamento que a gente tem levantado como é que que é é possível que o processo de evolução baseado em mutações
baseado em nas seleções naturais dessas mutações ou das características que as mutações provocaram tenha sido capaz de produzir uma modificação desse tipo não é só ficar parecido com a folha por exemplo a folha marrom o animal ficou marrom não é só isso é uma coisa muito muito mais complexa a ponto de imitar as características mais detalhadas da folha e até o enrolamento Então para que esse animal tenha conseguido do ponto de vista da evolução ter produzido essas mudanças ele teria que ficar neste ambiente um ambiente intacto sem mudanças para que as os fatores daquele ambiente
influenciassem as mutações e selecionasse as características dessas mutações de forma cumulativa até que elas todas acumuladas produzissem uma folha com esse nível de detalhe e até enrolado nenhum ambiente fica tempo suficiente intacto dessa forma quem é estudante de química e quem trabalha com isso sabe que pigmentos são moléculas altamente reativas são moléculas que T estruturas que conferem essas moléculas uma grande instabilidade por isso que elas são pigmentos eu fico F pensando no grande problema evolutivo que seria você guardar você compartimentar você isolar esses pigmentos responsáveis por uma determinada coloração é de modo que eles não
sofressem nenhum tipo de reação secundária que levaria a uma perda da propriedade de ser pigmento E se o organismo utilizasse apenas um tipo de pigmento já seria um problema agora ele tem uma série de pigmentos com classes químicas totalmente diferentes cuja a maneira de você preservar O pigmento a às vezes é totalmente oposta e contraditória você preservar O pigmento b e o mesmo organismo conserva os dois então do ponto de vista químico você criar as condições para preservação de pigmentos ao longo de todo um processo evolutivo de modo que estruturas surgiram gradualmente ao longo do
tempo do ponto de vista químico para mim isso é impossível a espécie de cavalos marinhos que habitam no meio de corais e Eles imitam os corais com muitos detalhes inclusive não só a cor mas o seu corpo tem a textura dos Corais com alguns grânulos que parecem pólipos imitam com perfeição os pólipos de corais nós temos o peixe pedra por exemplo que ele imita uma rocha de fundo de mar mas não só a rocha e sim os pedacinhos de algas e outras coisas que ficariam pregados na rocha ele imita tudo isso para passar despercebido paraas
suas presas além dessa característica que química de serem altamente reativos e necessitarem de uma determinada acomodação específica um ambiente específico para a estocagem a o fato desses pigmentos produzirem eh eh características produzirem formas e específicas e em um determinado ambiente e nos mostra o quanto eles foram projetados para desempenhar aquela função e existe um exemplo que Nós consideramos o exemplo modelo tem outros mas esse supera todos em que uma mosquinha ela tem nas suas asas em cada asa o desenho de uma aranha perfeito o formato a cor as pernas de uma aranha desenhadas detalhadamente em
cada uma das asas quando essa mosquinha pousa ela abre as asas transparentes e as aranhas aparecem como se estivessem ao lado dela então Aqueles predadores que comem a mosquinha mas temem Aranha não vão se aproximar dela porque tem as aranhas do lado as asas da mosca parecem uma aranha e então perceba existe uma intenção em representar um ser para que outro ser que o preda não se aproxime por medo então se isso fosse feito a longo de processo evolutivo e o bicho que desenvolveu aquilo precisaria imaginar a intenção de quem se aproxima dele isso para
mim é é impossível não pode acontecer e a pergunta que não quer calar quem desenhou essas aranhas nas asas desse inseto mutações casuais que foram gerando manchinhas marrons nas asas e a natureza foi selecionando ao longo de milhões de anos até que um dia por acaso como por Encanto essas manchinhas se combinaram formando a figura de uma aranha e a partir daí virou uma vantagem de sobrevivência não há como isso ter acontecido o que que a o processo naturalista fala Olha a seleção natural selecionou a seleção natural selecionou o quê o bicho que tinha a
melhor figura do bicho que tinha uma figura pior tudo bem a seleção natural poderia ter selecionado mas o que é o processo esquece de mencionar não é o Ah se tinha uma figura boa foi selecionada É como essa figura se formou é o como que a evolução não explica se você tivesse uma figura tudo bem poderia ser selecionada mas como essa figura surgiu não há mecanismos genéticos químicos viáveis para explicar a perfeição daquela figura a localização dos dos produtos químicos dos corantes as formas geométricas corretas e quem é que quem é que elaborou essas formas
quem é que visualizou Quais quais seriam aquelas formas que precisariam estar ali e a forma tem que parecer com um animal senão o Predador não dá bola nenhuma então a Ant evidência você teria que ter Ant evidência você teria que de antemão antes de criar aquela forma saber o que é que você quer fazer e esse é um caso típico de uma solução que precisaria ter sido elaborada antes do problema surgir antes de você imaginar que um Predador Venha porque se ele vier e você não tiver isso pronto foi-se então antes do Predador te atacar
você já tem que ter aquele sistema pronto um uma uma evidência Que processos naturais não guiados realmente não tem então mimetismo e camuflagem é uma grande evidência a favor do Design inteligente e ao mesmo tempo uma grande evidência contra processos naturais não guiados não há como esse fenômeno ter acontecido através de processos evolucionários isso é impossível não tem como a evolução ter produzido desenhos precisos de aranhas nas asas de uma mosca só é possível isso ter acontecido através de um design inteligente então será que eu gosto de ver design será que é a minha a
minha preferência em vez de design nisso inteligência ou será que são as evidências né que apontam como nunca antes que realmente existe uma inteligência eu gosto ou não Ou você goste ou não dessa conclusão a os dados nos forçam cada vez mais a admitir que essa inteligência existe realmente algo alguma ser consciente inteligente orquestrou tudo isso sincronizou tudo isso e capacitou esses bichos para se disfarçarem para que eles tivessem uma chance de sobreviver tornando a a a a a a as evidências da sua interferência no universo indesculpáveis através da mimetismo e a camuflagem por exemplo
como o bicho pau que tal qual bom ator incorpora até o balançar do graveto como o cavalo marinho que leva esculpidas em seu corpo nuan dos Corais onde habita nas mariposas que tem pintadas em suas asas cores e formas que instigam a imaginação Nossa e de outros seres que dela se afugentam na aparente natureza morta de uma folha de outono tão viva em sua arte no louva a deus que veste a mais bela e perfeita fantasia de flor por nós já vista seja para se esconder ou surpreender em cada um destes recursos do reino animal
a sofisticação e incrível riqueza de detalhes nos fascina e por serem protagonizados por aqueles que consideramos irracionais é impreterível refletir seria tudo isso destituído de intencionalidade ou uma razão maior orquestrando cada um destes processos com uma criativa colorida e multiforme [Música] [Música] Sinfonia
Related Videos

47:45
The Genetic Revolution: The Manipulation o...
space and science
941,576 views

3:22
Adaptações dos Seres Vivos
Camila Ferreira
100,373 views
25:49
Complexidade Irredutível | Origens #8
Origens NT
43,865 views

10:16
Unraveling the Great Butterfly Migration M...
Be Smart
667,911 views

24:58
A origem da humanidade | Raízes | Origens
Origens NT
4,695 views

44:31
Siberia, Relentless Nature!
Bom é Bicho
662,267 views

13:27
O QUE A CADEIRADA DO DATENA NO PABLO MARÇA...
Nós da Questão
169,448 views

10:47
What Makes Dragonflies So Extraordinary
PBS Terra
868,615 views

25:02
aula sobre mimetismo, camuflagem e coloraç...
Professor Hudy
934 views

14:24
CAMALEÕES! OS MAIORES E OS MENORES! CORES ...
ANIMAL TV
86,375 views

28:01
Seleção Natural e Adaptação | Filosofia da...
Origens NT
85,939 views

56:51
A evolução das aves: Os dinossauros que so...
ABC Terra
289,817 views

15:31
The Truth About Butterfly Metamorphosis (I...
Be Smart
548,751 views

28:01
Grandes Catástrofes | A Grande Catástrofe #10
Origens NT
82,436 views

27:08
Plantas Carnívoras
Alexandre Silva
1,160,420 views

18:33
The Evolution of the Giraffe
Animal Origins
468,283 views

37:11
The life of the forest. Fungi
Forest Film Studio
2,136,186 views

23:12
Descobrindo a Inteligência do Papagaio-Cin...
Origens NT
14,206 views

1:31:04
Botanical Science for Beginners
UF / IFAS Extension Pinellas County
60,525 views

24:52
A dispersão | Raízes | Origens
Origens NT
9,825 views